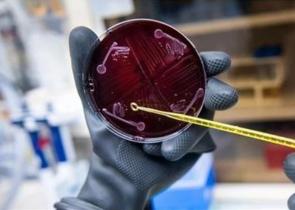

Aνθρώπινο μικροβίωμα δημιουργήθηκε σε εργαστήριο
Ανθρώπινο μικροβίωμα ανακοίνωσαν ότι κατάφεραν να δημιουργήσουν σε εργαστήριο επιστήμονες του Πανεπιστημίου Στάνφορντ στις ΗΠΑ. Είναι η πρώτη φορά...
Ανθρώπινο μικροβίωμα ανακοίνωσαν ότι κατάφεραν να δημιουργήσουν σε εργαστήριο επιστήμονες του Πανεπιστημίου Στάνφορντ στις ΗΠΑ. Είναι η πρώτη φορά...